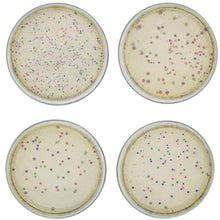
Load image into Gallery viewer, Edvotek 224 Rainbow Transformation result

Transformation is of central importance in molecular cloning since it allows for the selection, propagation, expression and purification of a gene. Positive selection for cells containing plasmid DNA is accomplished by antibiotic growth selection.
In this Edvotek experiment, your students will transform bacteria with a new set of rainbow colour plasmids that transform non-pathogenic bacterial cells into bright, colourful cells.
For 10 student groups.
Time required: Set Up & Plating 50 minutes, incubation - overnight, transformation efficiency 15 minutes.
Kit includes: instructions, cells, plasmid DNA, IPTG, ampicillin, transformation solution, ReadyPour Agar, Luria broth, petri dishes, sterile pipets, loops and microtubes. All you need: waterbath, 37C incubation oven, microwave or hot plate pGLO